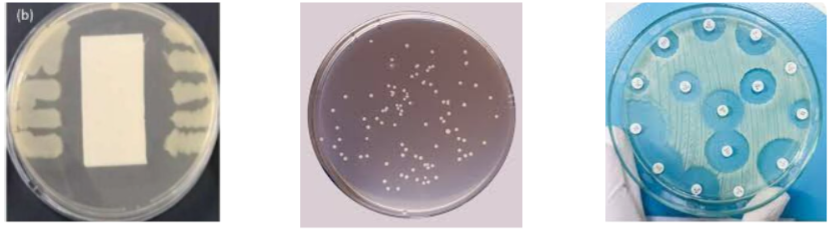

ศูนย์นาโนเทคโนโลยีแห่งชาติ (นาโนเทค) เปิดให้บริการวิเคราะห์ทดสอบ และบริการเทคนิคด้านนาโนเทคโนโลยี เพื่อเชื่อมโยงภาคเอกชนจากการใช้บริการวิเคราะห์ทดสอบหรือบริการเทคนิคมาสู่การทำวิจัย เช่น การวิเคราะห์ขนาด รูปร่าง และพื้นผิวของวัสดุนาโน การวิเคราะห์ด้านเคมี เช่น การตรวจสอบองค์ประกอบทางเคมีของตัวอย่าง และการวิเคราะห์ทางด้านชีวภาพ เช่น การทดสอบคุณสมบัติการฆ่าเชื้อแบคทีเรีย เป็นต้น สามารถรองรับตัวอย่างจากภาคอุตสาหกรรม ทั้งในกลุ่มอุตสาหกรรมสิ่งทอ พลาสติก อาหาร ยาและเครื่องสำอาง อุตสาหกรรมไฟฟ้า อิเล็กทรอนิกส์ เป็นต้น โดยได้รับมาตรฐานและได้รับการรับรอง ISO 9001 และ ISO/IEC 17025 โดยแบ่งหมวดการให้บริการ ดังนี้
1. การวิเคราะห์ขนาดและสัณฐานวิทยา [อัตราค่าบริการเริ่มต้น 500 บาท]
Dynamic Light Scattering (DLS)
- วิเคราะห์ขนาดอนุภาคที่กระจายตัวในสารละลายได้ในช่วง 0.3 นาโนเมตร ถึง 10 ไมโครเมตร และวิเคราะห์ประจุบนพื้นผิวของอนุภาค (Zeta potential) ที่อยู่ในสารละลายได้
- ได้รับการรับรอง ISO/IEC 17025 ในช่วงขนาด 50-1,000 นาโนเมตร
Mastersizer
- วิเคราะห์ขนาดของอนุภาคที่กระจายตัวในสารละลายได้ในช่วง 10 นาโนเมตร ถึง 3 มิลลิเมตร
Environment Scanning Electron Microscope (E-SEM)
- สามารถทำกำลังขยายได้สูงถึง 300,000 เท่า สามารถวิเคราะห์ดูโครงสร้างลักษณะทางกายภาพ และขนาดอนุภาคได้
- ได้รับการรับรอง ISO/IEC 17025 ในช่วงขนาด 100-1000 นาโนเมตร

Focused Ion Beam and Field Emission Scanning Electron Microscope (FIB and FE-SEM)
- สามารถทำกำลังขยายสูงถึง 1,000,000 เท่า สามารถวิเคราะห์ดูโครงสร้างลักษณะทางกายภาพ ขนาดอนุภาค และสามารถวิเคราะห์หาองค์ประกอบธาตุได้ด้วยเทคนิค EDX
- อุปกรณ์ FIB สามารถตัดตัวอย่างด้วยความละเอียดระดับนาโนเมตรเพื่อการตรวจวัดภายในเนื้อวัสดุ

Transmission Electron Microscope (TEM)
- สามารถทำกำลังขยายได้สูงถึง 1500000 เท่า และใช้อัตราเร่งอิเล็กตรอนได้สูงสุดที่ 200 kV สามารถวิเคราะห์ดูโครงสร้างภายใน ลักษณะทางกายภาพ ขนาดอนุภาค และสามารถวิเคราะห์หาองค์ประกอบธาตุได้ด้วยเทคนิค EDX

2. การวิเคราะห์พื้นผิว [อัตราค่าบริการเริ่มต้น 2,000 บาท]
Atomic Force Microscopy (AFM)
- วิเคราะห์สมบัติทางกายภาพของพื้นผิวตัวอย่างในระดับนาโนเมตร โดยสามารถวิเคราะห์รูปร่าง สมบัติทางกล และสมบัติทางไฟฟ้าได้
- ได้รับการรับรอง ISO/IEC 17025 ในช่วงขนาด 100-1,000 นาโนเมตร

Nano Mechanical Tester (NMT)
- Nano-indentation test: ใช้หัวกดที่มีขนาดเล็กในระดับนาโนเมตร ถึง ไมโครเมตร กดลงไปบนผิวตัวอย่างที่ต้องการตรวจวัดด้วยแรงที่กำหนด เพื่อศึกษาความแข็งแรง ความทนทานต่อแรงกดของผิวชิ้นงานหรือผิวเคลือบ
- Nano-scratch test: ใช้หัวกดลากไปบนผิวชิ้นงาน ด้วยแรงที่กำหนด เพื่อศึกษาความแข็งแรง ความทนทานต่อรอยขีดข่วนของผิวชิ้นงานหรือผิวเคลือบ
- Nano-wear test: ใช้หัวกดลากเป็นพื้นที่ ด้วยแรงกดที่กำหนด เพื่อศึกษาความแข็งแรง ความสามารถในการยึดติดของสารเคลือบหรือชั้นเคลือบของชิ้นงาน

Contact angle
- เทคนิคในการศึกษาสมบัติความชอบและไม่ชอบน้ำของพื้นผิวของตัวอย่าง โดยการหยดสารละลาย เช่น น้ำ แอลกอฮอล์ หรือสารเคมีอื่น ๆ ลงบนพื้นผิว และวัดมุมสัมผัสที่เกิดขึ้น
- วัด surface energy โดยการหยดสารละลายที่มีความเป็นขั้วที่ต่างกัน อย่างน้อย 3 ชนิด ลงบนผิวของตัวอย่าง และทำการคำนวณหาค่า surface energy

Brunauer-Teller (BET)
- วิเคราะห์พื้นที่ผิวของตัวอย่าง (surface area) วิเคราะห์หาขนาดเส้นผ่านศูนย์กลางของรูพรุน (pore size diameter) ปริมาตรของรูพรุน (pore volume) สำหรับตัวอย่างแบบผง
3. การวิเคราะห์ทางเคมี [อัตราค่าบริการเริ่มต้น 600 บาท]
Fourier Transform Infrared Spectroscopy (FTIR)
-
วิเคราะห์หมู่ฟังก์ชั่นของตัวอย่างโดยอาศัยการวัดการดูดกลืนรังสีอินฟราเรดทำให้หมู่ฟังก์ชั่นของสารเกิดการสั่นที่ความถี่แตกต่างกันโดยรายงานในรูปแบบเลขคลื่น หรือ wave numbers
Confocal Raman Spectroscopy
- Raman Spectroscopy คือเทคนิคในการวัดการสั่นของโมเลกุลซึ่งเป็นลักษณะเฉพาะ (vibrational characteristic) โดยการกระตุ้นด้วยแสงเลเซอร์ เพื่อศึกษาพันธะเคมี (chemical bond) และการกระจายตัวของสาร (chemical distribution) บนพื้นผิวตัวอย่าง
- confocal Raman spectroscopy คือ การตรวจวัด Raman spectrum ลึกลงไปในชั้นต่าง ๆ ของตัวอย่างที่ต้องการตรวจวัด เหมาะสำหรับตัวอย่างที่มีลักษณะเป็น core shell หรือ multi-layer coating เป็นต้น
Fluorescence Spectroscopy
- วัดการเรืองแสงของสาร โดยอาศัยการกระตุ้นจากแหล่งกำเนิดแสงและวัดแสงที่ได้จากการปลดปล่อยจากสารตัวอย่าง (emission) ช่วงความยาวคลื่นที่วัดได้คือ 200-900 นาโนเมตร

UV-Vis-NIR Spectroscopy
- วัดการดูดกลืนของแสง (absorptance) การทะลุผ่านของแสง (% transmittance) และการสะท้อนของแสง (% reflectance)
- ช่วงความยาวคลื่นที่วัดได้คือ 200-2000 นาโนเมตร
GC-MS (coupling Headspace), GC-MS/MS
- วิเคราะห์หาชนิดและปริมาณของสารประกอบเคมีอินทรีย์ที่ระเหยได้ เช่น การวิเคราะห์องค์ประกอบในน้ำมันหอมระเหย, สารสำคัญในพืชสมุนไพร, สารเคมีกลุ่ม pesticides, Napthalene, Phthalate และ VOCs ที่ตกค้างในอาหาร, บรรจุภัณฑ์ และสิ่งแวดล้อม รวมถึงสารประกอบไฮโดรคาร์บอนจากอุตสาหกรรมปิโตรเคมี เป็นต้น
HPLC and LC-MS/MS
- วิเคราะห์หาชนิดและปริมาณขององค์ประกอบในของผสมโดยใช้หลักการแยกสารโดยใช้ของเหลวเป็นตัวพาเปรียบเทียบผลที่ได้กับข้อมูลของสารมาตรฐาน เช่น การวิเคราะห์สารตกค้าง ยาฆ่าแมลง (Pesticides, Herbicides), สารปนเปื้อนในอาหาร และสิ่งแวดล้อม, สารเสพติด, ตัวอย่างทางการแพทย์, เภสัชกรรม และทางการเกษตร เป็นต้น
ICP-MS
- วิเคราะห์ธาตุและความเข้มข้นของธาตุโดยหลักการของอะตอมมิกสเปกโทรสโกปี
4. เทคนิคทางความร้อน [อัตราค่าบริการเริ่มต้น 500 บาท]
Differential Scanning Calorimetry (DSC)
- วิเคราะห์สมบัติทางความร้อนของวัสดุ จุดหลอมเหลว จุดเยือกแข็ง การเปลี่ยนสถานะ การระเหย วิเคราะห์อุณหภูมิการสลายตัว วิเคราะห์ปริมาณพลังงานที่ใช้ในการหลอมเหลว วิเคราะห์หาค่าของความจุความร้อนจำเพาะ (Cp)
Thermalgravimetric Analysis (TGA)
- วิเคราะห์หาความเสถียรของวัสดุเมื่อได้รับความร้อน เหมาะกับการวิเคราะห์ตัวอย่างที่เกี่ยวข้องกับการดูดซับแก๊สหรือการระเหยของน้ำ การตกผลึกอันเนื่องมาจากการเปลี่ยนสถานะ
Weathering testing oven, Q-SUN
- เครื่องจำลองสภาวะแสงแดดในสภาวะจริง จำลองความชื้นด้วยระบบควบคุมความชื้น สามารถจำลองช่วงสเปกตรัมของแสงแดดได้ทั้งหมด ครอบคลุมทั้ง UV, Visible light และ infrared
UV accelerated weathering tester, QUV
- เครื่องเร่งสภาวะอากาศในช่วงแสงยูวี เป็นการจำลองสภาวะอากาศให้วัสดุเสื่อมสภาพหลังจากมีการใช้งานเป็นระยะเวลานาน เหมาะกับงานทดสอบความทนทาน อย่างเช่น หลังคา งานเคลือบ งานพลาสติก เป็นต้น

5. การวิเคราะห์ทดสอบทางจุลชีววิทยา [อัตราค่าบริการเริ่มต้น 1,500 บาท]
บริการทดสอบประสิทธิภาพการยับยั้งเชื้อแบคทีเรีย ตามมาตรฐานสากล โดยเชื้อที่ใช้ในการทดสอบมีดังนี้ Staphylococcus aureus, Escherichia coli, Klebsiella pneumoniae, Pseudomonas aeruginosa
การวิเคราะห์เชิงคุณภาพ [อัตราค่าบริการเริ่มต้น 1,500 บาท]
- AATCC 147 Textile materials: Clear zone of inhibition
- JIS L 1902 Textile materials: Colony plate count method
- CLSI M2-A11 Clear zone by Disc-diffusion method
การวิเคราะห์เชิงปริมาณ [อัตราค่าบริการเริ่มต้น 3,000 บาท]
- AATCC 100 Antimicrobial fabric test (% reduction)
- JIS Z 2801 and ISO 22196 Antimicrobial activity of plastics and other non-porous surfaces (% reduction)
- CLSI M7-A9 (MIC/MBC) Minimal inhibitory concentrations
- ASTM E 2149 Antimicrobial activity of antimicrobial agents under dynamic contact conditions (% reduction)
- ISO 27447 Test for Antimicrobial activity of photocatalytic materials
ดาวน์โหลดรายละเอียด :
อัตราค่าวิเคราะห์ทดสอบ (Price List)
** ห้องปฏิบัติการมีนโยบายไม่ตัดสินผลการทดสอบ และมีนโยบายไม่สุ่มตัวอย่างเพื่อการวิเคราะห์และทดสอบ **
แบบฟอร์มขอรับบริการเครื่องมือ
Form1 (Instrument)
แบบฟอร์มขอรับบริการทดสอบ Anti-bacterial
Form2 (Antibac)
Sample preparation guidelines for analysis
ข้อมูลสำหรับการเตรียมตัวอย่างสำหรับการวิเคราะห์ทดสอบ
ติดต่อขอรับบริการได้ที่ :
งานบริการโครงสร้างพื้นฐาน
ศูนย์นาโนเทคโนโลยีแห่งชาติ (NANOTEC)
143 อาคาร INC 2 (B) อุทยานวิทยาศาสตร์ประเทศไทย
ถ.พหลโยธิน ต.คลองหนึ่ง อ.คลองหลวง จ.ปทุมธานี 12120
โทร. 0 2564 7100 ต่อ 6517, 6625 Email: bdis-infs@nano.toolsmkt.com
